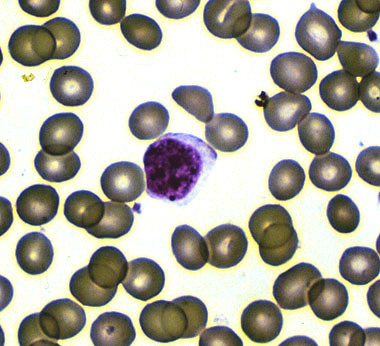

Normal lymphocyte, peripheral blood smear.
Click picture to enlarge. Close window to return
Normal lymphocytes are approximately 9-12 microns in size, and have scant cytoplasm and round to oval nuclei with dense chromatin. In adults, 20-50% of peripheral blood WBC's are lymphocytes, which are predominantly T cells, with a normal CD4:CD8 ratio of 2:1.